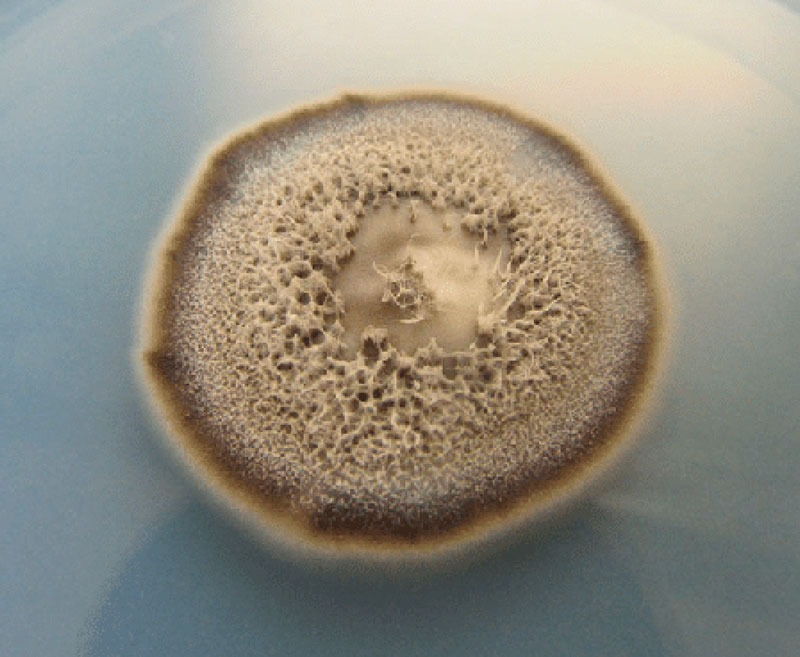

Gremião, I. D. F. et al. Brazilian Journal of Microbiology. 2020Sporothrix brasiliensis se propaga en gatos y humanosGremião, I. D. F. et al. Brazilian Journal of Microbiology. 2020
Una nueva enfermedad se está propagando en Brasil: la esporotricosis, una micosis causada por hongos del género Sporothrix, que ingresan al organismo a través de lesiones en la piel. Los análisis genéticos indican una epidemia en curso en Brasil, causada principalmente por el hongo S. brasiliensis. Ya se han registrado transmisiones entre animales y entre animales y humanos. De las 72 muestras de varias especies de Sporothrix examinadas, recolectadas entre 2013 y 2022, 55 eran de esporotricosis humana y 17 de animales, mayormente gatos, que son los principales transmisores, de las cuales 67 eran de Brasil, 3 de Estados Unidos y 2 de Colombia. En otro estudio, un grupo conformado por investigadores de las universidades Federal Rural de Pernambuco (UFRPE) y Federal de São Paulo (Unifesp) identificó 1.176 casos de esporotricosis en gatos en los municipios de Jaboatão dos Guararapes, Olinda y Recife, todos en el estado de Pernambuco, entre 2026 y 2021. Según el análisis genético que se llevó a cabo, la especie predominante, S. brasiliensis, podría ser procedente de Río de Janeiro. En gatos y perros, la micosis causa heridas, principalmente en hocico, orejas y patas. En los seres humanos, la lesión inicial se parece a la picadura de un insecto; puede desaparecer en forma espontánea o bien afectar los pulmones causando tos, dificultad respiratoria, fiebre y dolor al respirar. Se trata con medicación antimicótica por un período que va de tres a seis meses, en promedio (Lancet Microbe, marzo; Mycopathologia 14 de julio).
Republicar